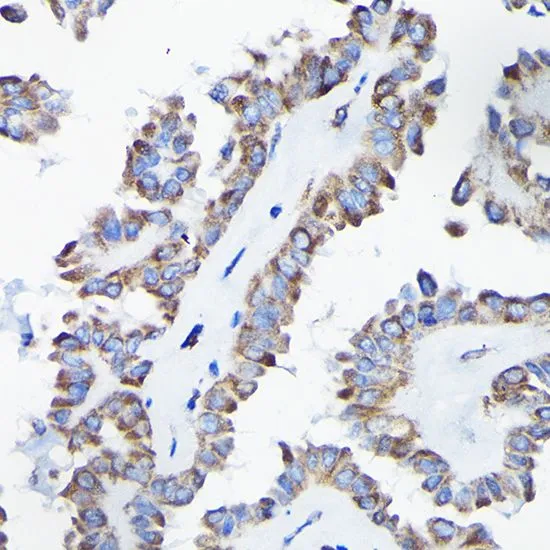

WB analysis of normal (control) and knockout (KO) 293T cell lysate using GTX32428 AIF antibody. Dilution : 1:1000 Loading : 25microg per lane
AIF antibody
GTX32428
ApplicationsImmunoFluorescence, Western Blot, ImmunoCytoChemistry, ImmunoHistoChemistry, ImmunoHistoChemistry Paraffin
Product group Antibodies
TargetAIFM1
Overview
- SupplierGeneTex
- Product NameAIF antibody - KO/KD Validated
- Delivery Days Customer9
- Application Supplier NoteWB: 1:500 - 1:2000. ICC/IF: 1:50 - 1:200. IHC-P: 1:50 - 1:200. *Optimal dilutions/concentrations should be determined by the researcher.Not tested in other applications.
- ApplicationsImmunoFluorescence, Western Blot, ImmunoCytoChemistry, ImmunoHistoChemistry, ImmunoHistoChemistry Paraffin
- CertificationResearch Use Only
- ClonalityPolyclonal
- ConjugateUnconjugated
- Gene ID9131
- Target nameAIFM1
- Target descriptionapoptosis inducing factor mitochondria associated 1
- Target synonymsAIF, AUNX1, CMT2D, CMTX4, COWCK, COXPD6, DFNX5, NADMR, NAMSD, PDCD8, SEMDHL, apoptosis-inducing factor 1, mitochondrial, apoptosis-inducing factor, mitochondrion-associated, 1, auditory neuropathy, X-linked recessive 1, programmed cell death 8 (apoptosis-inducing factor), striatal apoptosis-inducing factor, testicular secretory protein Li 4
- HostRabbit
- IsotypeIgG
- Protein IDO95831
- Protein NameApoptosis-inducing factor 1, mitochondrial
- Scientific DescriptionThis gene encodes a flavoprotein essential for nuclear disassembly in apoptotic cells, and it is found in the mitochondrial intermembrane space in healthy cells. Induction of apoptosis results in the translocation of this protein to the nucleus where it affects chromosome condensation and fragmentation. In addition, this gene product induces mitochondria to release the apoptogenic proteins cytochrome c and caspase-9. Mutations in this gene cause combined oxidative phosphorylation deficiency 6 (COXPD6), a severe mitochondrial encephalomyopathy, as well as Cowchock syndrome, also known as X-linked recessive Charcot-Marie-Tooth disease-4 (CMTX-4), a disorder resulting in neuropathy, and axonal and motor-sensory defects with deafness and cognitive disability. Alternative splicing results in multiple transcript variants. A related pseudogene has been identified on chromosome 10. [provided by RefSeq, Aug 2015]
- Storage Instruction-20°C or -80°C,2°C to 8°C
- UNSPSC12352203

![ELISA analysis of antigen using GTX60476 AIF antibody [4E7]. Red : Control antigen 100ng Purple : Antigen 10ng Green : Antigen 50ng Blue : Antigen 100ng](https://www.genetex.com/upload/website/prouct_img/normal/GTX60476/GTX60476_20170912_ELISA_w_23061123_899.webp)
![IHC-P analysis of hmuan oophoroma tissue section using GTX00833 AIF antibody [GT1143]. Dlution : 1:100](https://www.genetex.com/upload/website/prouct_img/normal/GTX00833/GTX00833_20191101_AP_003_42_w_23053121_674.webp)
